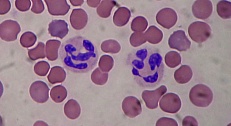

Токсический синовит. Информация для пациентов
Что такое токсический синовит?
Токсический синовит – это временное самопроизвольно проходящее заболевание, которое вызывает боль в бедре у детей. Он также известен как транзиторный синовит. По современным представлениям, это заболевание является ведущей причиной боли в бедре у детей. Заболевают в основном дети младше 8 лет. Обычно проходит без лечения в течение 10 дней.
Что вызывает токсический синовит?
Вирусная инфекция, которая поражает синовиальную оболочку сустава – обычно является причиной токсического синовита. Она приводит к отеку и воспалению в пораженном суставе, и может распространиться на другие суставы с течением времени.
Каковы симптомы токсического синовита?
Наиболее распространенным симптомом токсического синовита является боль в бедре. Эта боль может возникнуть как в одном бедре, так и в обоих сразу. Она может впервые возникнуть после того, как ребенок долго лежал, или сидел в одном положении.
Другие симптомы:
- хромота или хождение на цыпочках в связи с дискомфортом
- боль в тазобедренном или коленном суставе, реже – в других суставах
- субфебрильная температура, не выше 38 градусов
- полный отказ вступать на ногу в случае выраженного болевого синдрома
- плач и беспокойство у детей младшего возраста
Особенности у младенцев
Отличительные признаки токсического синовита от других причин боли в бедре
Токсический синовит бывает трудно диагностировать. Есть другие причины боли в бедре, гораздо более опасные и тяжелые, чем транзиторный синовит. Поскольку эти причины требуют активного лечения - следует сперва исключить их, а уже потом ставить диагноз транзиторного синовита. К ним относятся:
Септический артрит
Это заболевание вызвано бактериальной или грибковой инфекцией, которая приводит к воспалению суставов. Это может привести к хроническому артриту и стойкому нарушению подвижности в суставе, пори отсутствии правильного и своевременного лечения.
Болезнь Легга-Кальве-Пертеса
Это заболевание возникает, когда приток крови к тазобедренному суставу – слишком мал. Это приводит к разрушению сустава из-за отмирания костной ткани.
Болезнь Лайма
Это бактериальная инфекция, передаваемая в основном через укусы иксодовых клещей. Способна приводить к тяжелым долгосрочным последствиям, как суставным, так и внесуставным, при отсутствии своевременного адекватного лечения.
Эпифизеолиз
Это состояние возникает, когда разрушается ростковый эпифизарный хрящ кости. В будущем это может приводить к разной длине конечностей, а также к тяжелому остеоартрозу.
Как диагностируется токсический синовит?
Осмотр
Детский врач выполнит физикальный осмотр, чтобы выяснить, какие именно движения вызывают боль. Он будет сгибать и вращать конечности в суставах, измерять размеры суставов, осматривать и ощупывать их – пытаясь найти признаки воспаления, и исключить более тяжелые болезни, чем транзиторный синовит.
УЗИ
Ультразвуковое исследование тазобедренного сустава может быть проведено ребенку для того, чтобы убедиться в отсутствии жидкости в суставе, которая является признаком воспаления.
Анализы крови
Анализы крови (как общие, так и специфические) могут потребоваться для определения выраженности воспалительной реакции, и исключения иных причин артрита, таких как лайм-боррелиоз.
Пункция сустава
Детский врач может пунктировать – то есть ввести иглу в полость сустава ребенка для получения образца синовиальной жидкости, и затем отправить ее на исследование в лабораторию. Это исследование делается не всем детям, а только при подозрении на опухоль, или септический артрит.
Рентгенография сустава
Детский врач может назначить рентгенологическое исследование, чтобы исключить болезнь Легга-Кальве-Пертеса, эпифизеолиз, а также травму кости.
Лечение токсического синовита
Лечение токсического синовита включает в себя ограничение нагрузки на сустав и снятие боли. Воспаление, вызванное вирусной инфекцией, проходит само по себе, и не требует специфической терапии.
Лекарства
Такие препараты, как ибупрофен и напроксен могут помочь временно уменьшить воспаление и боль. Врач может назначить и более серьезные анальгетики, продающиеся только по его рецепту, если безрецептурных средств не будет достаточно для облегчения боли.
Покой
Необходимо максимально разгрузить пораженный сустав. Обычно ходьба безопасна, однако бег, контактные виды спорта, прыжки и прочие занятия с большой нагрузкой на сустав – должны быть запрещены до полного выздоровления. Поднятие тяжестей также крайне нежелательно.
Прогноз
Токсический синовит проходит самостоятельно в большинстве случаев к 10му дню, хотя иногда он длится и до пяти недель. У некоторых детей он может повторяться через какое-то время, особенно после ОРВИ.
Опасные ситуации: когда я должен обратиться к врачу незамедлительно?
Хотя эти ситуации крайне редки, вам следует о них знать, и при столкновении с ними – немедленно обратиться к врачу:
- Если лихорадка или боль становятся все сильнее, несмотря на прием болеутоляющих и жаропонижающих
- Боль в суставах длится дольше трех недель, или возвращается, как только ребенок перестает пить лекарства
- Вы не видите никакого эффекта от противовоспалительных препаратов спустя несколько дней после их назначения
Узнав об этих симптомах, детский врач, возможно, назначит дополнительные анализы и обследования, чтобы исключить более опасные заболевания, чем токсический синовит.